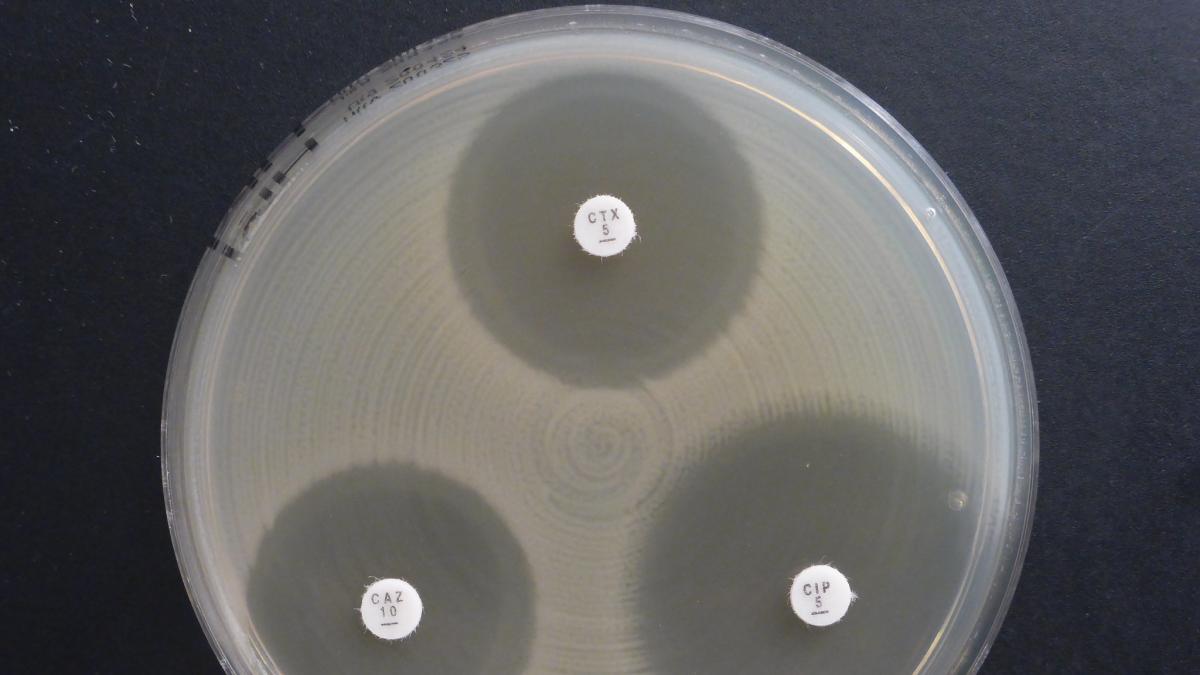

More on Health
-
-

-

-

-

-
06 December 2023 09:00-10:30Food Systems Pavillion Side event
GMT +04:00Putting farmers first: How can we ensure the future of farming and food amidst the climate crisis?
-
06 December 2023 17:00-18:30Side event
GMT +04:00Dietary justice: Can we achieve climate and nutrition goals with animal agriculture?
-
10 December 2023 15:15-16:00Food4Climate Pavillion Side event
GMT +04:00Tackling the Intractable: the Political Economy of a Livestock Transition in Line with Climate Goals
-
08 December 2023 15:30-16:10Agri-food systems summit Climate Action Innovation Zone in the Madinat Jumeirah Side event
GMT +04:00Health is wealth: Prioritising the consumer
-
05 December 2023 11:30-13:00SE Room 9 Side event
GMT +04:00How animal-sourced foods nourish the world in times of climate change
-
 Video
VideoOnly ONE Health
-

-
-
-
-
-
-
-
-
-
-
-
-
-
-
-
-
-
-
-
-
-
-
-
-
-
-
-
-
-
-
-
-
-
-
-
-
-
-
-
-
-
-
-
-
-
-
-
-
-
-
-
-
-
-
-
Investment opportunity Action areas - Animal welfare
-
-
-
-
-
-
-
-
-
Investment opportunity Animal health and welfare
-
-
-
-
-
-
-
-
Investment opportunity Environment health
-

Investment opportunity One Health
-
-
Investment opportunity Antimicrobial resistance
-
Investment opportunity Emerging diseases
-
-
-
-
-
Investment opportunity Prevent zoonotic diseases
-
Investment opportunity Raise food safety
-